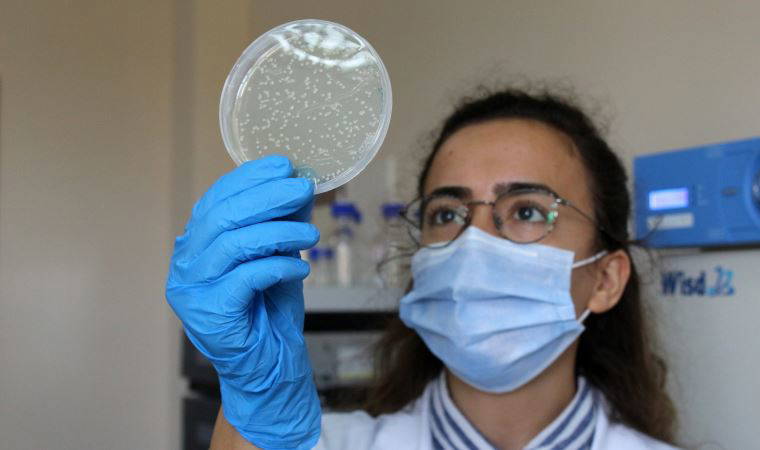
Koronavirüse karşı geliştirilen 5 aşı, insanlar üzerinde denenecek

İspanya’daki Barselona Üniversitesi'nden bilim insanlarının yürüttüğü yeni bir araştırma, koronavirüs taşıyan bazı kişilerin, daha yaygın semptomlar ortaya çıkmadan önce burunla ilgili bir dizi belirti yaşadığını keşfetti.
Araştırmada, burun kuruluğu gibi erken belirtilerin aslında koronavirüs hastalarında sık görülen tat ve koku kaybının habercisi olabileceği ortaya kondu.
Independent Türkçe'nin aktardığı habere göre, bulgularını Merdxiv isimli baskı öncesi platformda yayımlayan araştırmacılar, 35 Kovid hastasından oluşan bir grupla birlikte yaş ve cinsiyet açısından onlara denk bir kontrol grubunu ankete tabi tuttu. Katılımcılar, kendilerine yöneltilen sorulara sadece evet ya da hayır cevabı verdi.
Henüz hakem onayından geçmeyen çalışmada hastaların yüzde 68'inden fazlası, burunla ilgili en az bir semptom bildirdi.
Koronavirüs testi pozitif olan grubun "burunda garip bir his" deneyimlediği ve “aşırı kuruluk” gibi belirtileri kontrol grubuna kıyasla daha fazla bildirdiği ortaya çıktı.
Bunun yanında hastaların yüzde 52’si, sürekli burnunu yıkamış gibi hissettiğini aktardı. Kontrol grubunda aynı hissi yaşadığını söyleyenlerin oranıysa yüzde 3’te kaldı.
Araştırmacılara göre burunda hissedilen bu belirtiler, ağırlıklı olarak koku ve tat kaybıyla birlikte görüldü. Ayrıca Covid-19’un diğer belirtilerinden önce veya onlarla birlikte ortaya çıktığı ve ortalama 12 gün sürdüğü ifade edildi.
Araştırmacılar, bu erken belirtilerin keşfinin önemini şu sözlerle açıkladı:
Bu nazal (burunla ilgili) semptomların varlığı ve erkenden ortaya çıkması, Covid-19'un erken teşhisini kolaylaştırabilir.